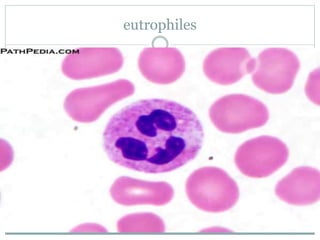
eutrophiles
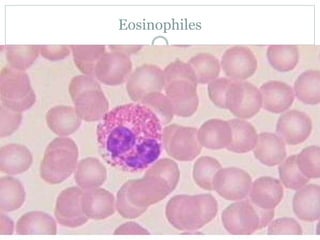
Eosinophiles
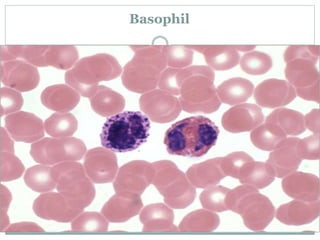
Basophil
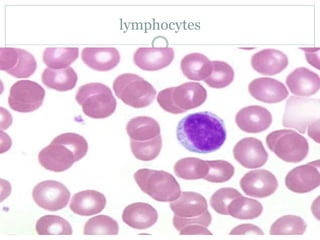
lymphocytes
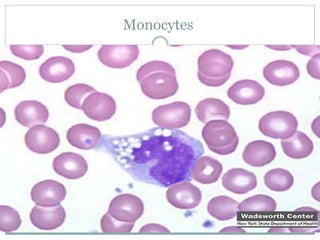
Monocytes

Embed presentation
Downloaded 21 times



















































































![Conective[1]](https://image.slidesharecdn.com/qwpsm6rts2ekluwwa6mk-signature-4c28f0f13a30c4ea316a9d58353990586de4897ab085203d01a9b7b7228e72f9-poli-180213061217/85/Conective-1-84-320.jpg)
![Conective[1]](https://image.slidesharecdn.com/qwpsm6rts2ekluwwa6mk-signature-4c28f0f13a30c4ea316a9d58353990586de4897ab085203d01a9b7b7228e72f9-poli-180213061217/85/Conective-1-85-320.jpg)

This document summarizes the different types of cells and fibers found in connective tissue. It describes fibroblasts, adipocytes, macrophages, mesenchymal cells, pericytes, endothelial cells, reticular cells, mast cells, white blood cells, melanophore pigment cells, and the types of connective tissue including areolar, adipose, yellow elastic, white collagenous, and reticular tissue. It also lists the three main types of connective tissue fibers as white collagenous fibers, yellow elastic fibers, and reticular fibers. Finally, it mentions hyaline cartilage, chondroblasts, and elastic cartilage.

![Conective[1]](https://image.slidesharecdn.com/qwpsm6rts2ekluwwa6mk-signature-4c28f0f13a30c4ea316a9d58353990586de4897ab085203d01a9b7b7228e72f9-poli-180213061217/85/Conective-1-84-320.jpg)
![Conective[1]](https://image.slidesharecdn.com/qwpsm6rts2ekluwwa6mk-signature-4c28f0f13a30c4ea316a9d58353990586de4897ab085203d01a9b7b7228e72f9-poli-180213061217/85/Conective-1-85-320.jpg)